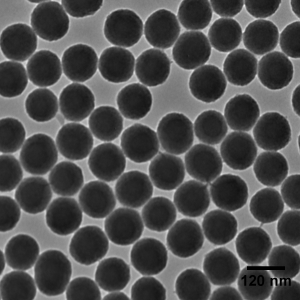
Solid Silica in Ethanol - Silica Nanospheres - Aminated - 120 nm, 10 mg/mL

[annasta_filters preset_id=1]
Silica Nanoparticles in Ethanol
Repeatable, batch to batch, Silica particle Diameter size
Silica nano-particles are spherical in design and very uniform in size
Typical <3% Peak Size Distribution Width above 100nm
40nm to 2um Siz…
In stock
Repeatable, batch to batch, Silica particle Diameter size
Silica nano-particles are spherical in design and very uniform in size
Typical <3% Peak Size Distribution Width above 100nm
40nm to 2um Sizes available with 15ml of Di Water and 10% SiO2 concentration
40nm to 30um Sizes available in 1Kg increments of Dry Silica nanoparticles
Ultra-High Size Purity of 99.997 percent
Refractive Index of SiO2 (n=1.46), very close to Polystyrene Latex (n=1.585) @ 633nm laser wavelength
Calibration Curves between SiO2 and PSL Spheres is cose, allowing highly accurate, SiO2 size calibration
Additional information
| Model | 100ml, 15ml |
|---|